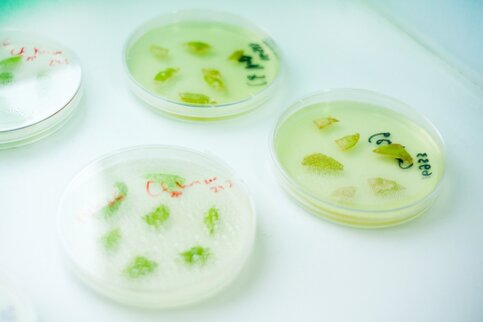

Фото: M24.ru/Лидия Широнина
Распространение коронавируса ближневосточного респираторного синдрома (MERS) не является чрезвычайной ситуацией, говорится в заявлении Чрезвычайного комитета Всемирной организации здравоохранения.
По мнению ВОЗ, условия для подобного статуса еще не были достигнуты. Однако комитет отметил, что на данный момент существует много пробелов в знаниях, касающихся передачи вируса MERS между людьми, поэтому организация рекомендует воздержаться от необязательных поездок в зону
заражения.
Отметим, что всего в Южной Корее от коронавируса ближневосточного респираторного синдрома скончались уже 20 человек, инфицированы еще 162.
Ранее M24.ru сообщало, что Россия уже некоторое время разрабатывает вакцину против коронавируса MERS. Об этом заявляла вице-премьер РФ Ольга Голодец.
Она также отметила, что существуют опасения в связи с распространением коронавируса в мире, однако угрозы эпидемии в России в настоящее время нет.
Напомним, во вторник стало известно, что в Германии умер носитель MERS, который стал первым скончавшийся от коронавируса в Европе. Между тем, как утверждает ВОЗ, распространение вируса в Южной Корее ограничивается медицинскими учреждениями, где находятся его носители.
Эта особенность характерна не только для штамма MERS, но и для всего семейства коронавирусов. Все они воздействуют на верхние дыхательные пути и течение болезни, вызываемых большинством вирусов семейства, похожи на простуду или другую легкую респираторную инфекцию.
Несмотря на то, что MERS – единственный штамм, который является смертельно опасным для человека, вакцины от него, пока, не существует. В мире, по данным Всемирной организации здравоохранения (ВОЗ) на 12 июня, зафиксировано 1289 случаев заражения вирусом MERS, скончались 455 человек.








Собянин: суперколледж в стиле русского авангарда появится в Коммунарке



























